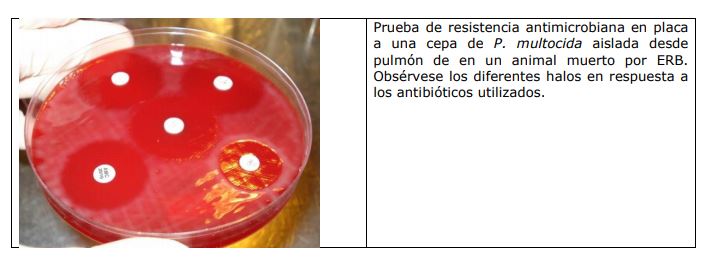

En el caso de la enfermedad respiratoria bovina la realización de un diagnóstico adecuado es clave para identificar los agentes actuantes y, así implementar los tratamientos específicos. De esta forma se evitará la aparición de bacterias resistentes a los antibióticos más utilizados.
Como sucedió en otros países, la intensificación de los sistemas productivos para el abastecimiento de la industria cárnica generó nuevos desafíos sanitarios ya que el aumento de la carga animal instantánea (animales por unidad de superficie), favoreció la presentación de enfermedades, mayormente infecciosas como es el caso de las neumonías, repercutiendo negativamente en los sistemas. La enfermedad respiratoria bovina (ERB) es un proceso infeccioso multifactorial, causado principalmente por virus (herpes virus bovino-1, parainfluenza-3, virus sincitial respiratorio, virus de la diarrea viral bovina), bacterias (Pasteurellamultocida, Mannheimiahaemolytica, Histophilussomni)y parásitos (Dictyocaulusviviparus).
La ERB generalmente afecta a los bovinos menores de dos años de edad en engordes a corral (feedlots), siendo una de las principales causas de morbilidad y mortalidad (enfermedad y muerte, respectivamente) en esta categoría. Si bien el sistema a corral es el más afectado, la intensificación de los engordes pastoriles ha llevado a un aumento en la presentación de neumonías en dichos sistemas. La Facultad de Ciencias Veterinarias de Tandil y el Grupo de Sanidad Animal del INTA Balcarce, desde hace dos años, estamos llevando a cabo un trabajo en conjunto que consiste en el seguimiento de las problemáticas sanitarias que se presentan en feedlots ubicados en provincia de Buenos Aires (partidos de Tandil, Balcarce y Ayacucho, principalmente). La mayoría de los establecimientos que ingresan a este seguimiento tienen antecedentes de ERB, y otros son considerados de bajo riesgo, debido a la escasa morbilidad que presentan los animales. Este tipo de trabajo nos permite estar en estrecho contacto con los productores y los responsables sanitarios de los establecimientos, recibiendo consultas para ir a realizar necropsias en las que se toman diferentes muestras para llevar a cabo un correcto diagnóstico de estos casos. Resultados preliminares, indican que la tasa de letalidad (muertos sobre el total de la población) de la ERB oscila alrededor del 1 a 2%, dependiendo de factores como: número de animales por corral, tipo y forma de alimentación, el piso, el manejo, condiciones climáticas y sanidad implementada, entre otros.
A partir de los datos recabados hasta el momento podemos decir que el diagnóstico de ERB representó el 45% de las necropsias realizadas. Si bien ello indica que la ERB es una causa de enfermedad y muerte importante en nuestros sistemas, llama la atención que en el 90% de las necropsias realizadas se había reportado signología respiratoria, además de implementarse uno o más tratamientos antibióticos, sin el correcto diagnóstico. Cuando evaluamos en qué momento se presentan los casos de ERB, observamos que se producen dentro de los primeros 30 días de ingresados los animales a los corrales en aquellos establecimientos en los que no se realiza profilaxis (aplicación de antibiótico a toda la tropa al ingreso). Mientras que en los establecimientos en que se utilizan maniobras de profilaxis, los casos se presentan igualmente, pero posterior a los 30 días. Otro dato de importancia que surge de los análisis, es que la ERB se presenta mayormente en animales comprados en feria, donde se desconoce la sanidad previa, mientras que lotes de animales de sanidad conocida, donde se han aplicado correctamente las vacunas contra neumonías y no sufren el estrés de la feria, tienen menor casuística de presentación de la enfermedad. La ausencia de un diagnóstico adecuado incide de manera directa en la falla en los tratamientos. Si a esto le sumamos la falta de identificación de los agentes actuantes y la implementación de tratamientos empíricos, la situación favorece a la aparición de bacterias resistentes a los antibióticos más utilizados.
Si consideramos que en otros países está reportado que el tratamiento farmacológico representa hasta el 8% del total de los costos de producción, con alto porcentaje de fracasos terapéuticos, esto tiene una repercusión importante en la rentabilidad de nuestros sistemas.
En nuestra experiencia,el 21% de las bacterias aisladas presentaron resistencia al menos a uno de los antibióticos evaluados, siendo los más frecuentes los macrólidos (Eritromicina), las fluorquinolonas (Enrofloxacina), Tetraciclinas (Oxitetraciclina), Beta lactámicos (Ceftriaxona, Amoxicililina sola o combinada con Ácido Clavulánico) y aminoglucósidos (Gentamicina). Estos resultados, si bien son preliminares, y en los cuales nos encontramos trabajando, son un llamado de atención para los actores del sistema rural ya que la resistencia a los antibióticos se propaga en forma bidireccional entre los animales y el hombre utilizando el ambiente como nicho. En nuestro trabajo hemos encontrado bacterias resistentes a más de un grupo farmacológico e incluso a fármacos que no tienen utilización en sistemas de engorde a corral lo cual nos hace plantearnos la posibilidad de estar frente a la aparición de bacterias multiresitentes que no son comunes en Medicina Veterinaria y que podrían provenir del ambiente, siendo diseminadas por las personas a través de las manos, boca, materia fecal, etc.
Por lo planteado, consideramos necesario difundir estrategias para optimizar una terapia antimicrobiana basada en diagnósticos certeros, junto a la instauración de tratamiento antibiótico sólo cuando realmente sea necesario y en el período de inicio de la enfermedad. Para esto es necesaria la presencia de un Veterinario capacitado, que recorra a diario los corrales, junto al acompañamiento del personal a cargo, para detectar animales en estadios tempranos de la ERB.
¿Cómo identificar animales enfermos y qué hacer?
Al comienzo de la enfermedad los animales presentan signos leves de depresión que pueden estar de pie o acostarse, aislados de otros animales, con orejas o cabeza caída, presentando respuesta al estímulo y movilidad y que exhiben deshidratación leve (apariencia hundida de los ojos), descarga nasal y ocular serosa, tos seca y/o frecuencia respiratoria elevada y salivación sutil. Este es el momento en el que el Veterinario debe realizar un correcto diagnóstico, apartarlo del resto del lote e implementar un tratamiento adecuado. En cambio, cuando ya vemos animales con signos similares de orejas y cabeza caídas, con respuesta más lenta al estímulo, con dificultad para levantarse y para caminar, mayor deshidratación, descarga nasal y ocular purulenta o mucopurulenta, tos productiva, respiración forzosa y salivación excesiva, la posibilidad de recuperación pos-tratamiento decae drásticamente. Hasta el momento la posibilidad diagnóstica sobre el animal vivo de ERB está limitada a la detección temprana de la signología descripta anteriormente y la medición de la temperatura. Este es un punto de importancia ya que es una herramienta de fácil utilización y que bien tomada, nos arroja datos certeros, pudiendo inferir si el animal cursa con un proceso infeccioso o no. Por lo mencionado, la recorrida diaria de los corrales, la separación de los afectados de manera temprana y la implementación de un tratamiento adecuado por parte del Veterinario, ayudan a minimizar el contagio en y entre los corrales, y mejora la recuperación de los animales afectados.
¿Hay forma de prevenir o minimizar la aparición de ERB?
Sí, mejorando la inmunidad de los animales mediante la utilización de vacunas adecuadas, de buena calidad y, que tengan los agentes involucrados en la ERB. Los planes sanitarios deben ser realizados por un profesional Veterinario de acuerdo a cada caso en particular. Lo ideal es aplicar dos dosis de esta vacuna previo al destete con un intervalo adecuado entre dichas dosis, provocando que la respuesta inmunitaria perdure en el tiempo, de esta forma estamos entregando al engorde un ternero preacondicionado. Cuando se compran animales en ferias, sin antecedentes sanitarios, lo ideal es formular un plan que les asegure a los animales una buena estimulación de la respuesta inmunitaria; para esto es necesario que la tropa descanse al ingreso para disminuir el estrés antes de realizar la sanidad. Siempre se deberán considerar los estándares de bienestar animal dentro de los corrales, respetando el número de animales por m2 , el espacio de frente de comedero de acuerdo a la categoría de engorde, asegurar un piso adecuado compacto y con drenaje, aporte de agua apta para consumo animal y bebederos en condiciones, contemplando la posibilidad de generar sombra para minimizar el estrés térmico, entre otros.
Consideraciones finales
La ERB es una enfermedad de relevancia económica en nuestros sistemas de engorde a corral, siendo de vital importancia el accionar de los Veterinarios de actividad privada con el objetivo de realizar un diagnóstico adecuado y la implementación de tratamientos acordes a la problemática. Por otro lado, en Argentina, la información sobre resistencia de las bacterias actuantes en la ERB es escasa con lo cual desde la Facultad de Ciencias Veterinarias de Tandil y el INTA Balcarce estamos generando información que permitirá concientizar sobre el uso racional de los antibióticos, así como alertar acerca de la relación directa entre el empleo indiscriminado de tales fármacos con la aparición y permanencia de cepas bacterianas resistentes.
Fuente: INTA por María Andrea Fiorentino, Guadalupe de Yaniz y Sergio Sanchez Bruni